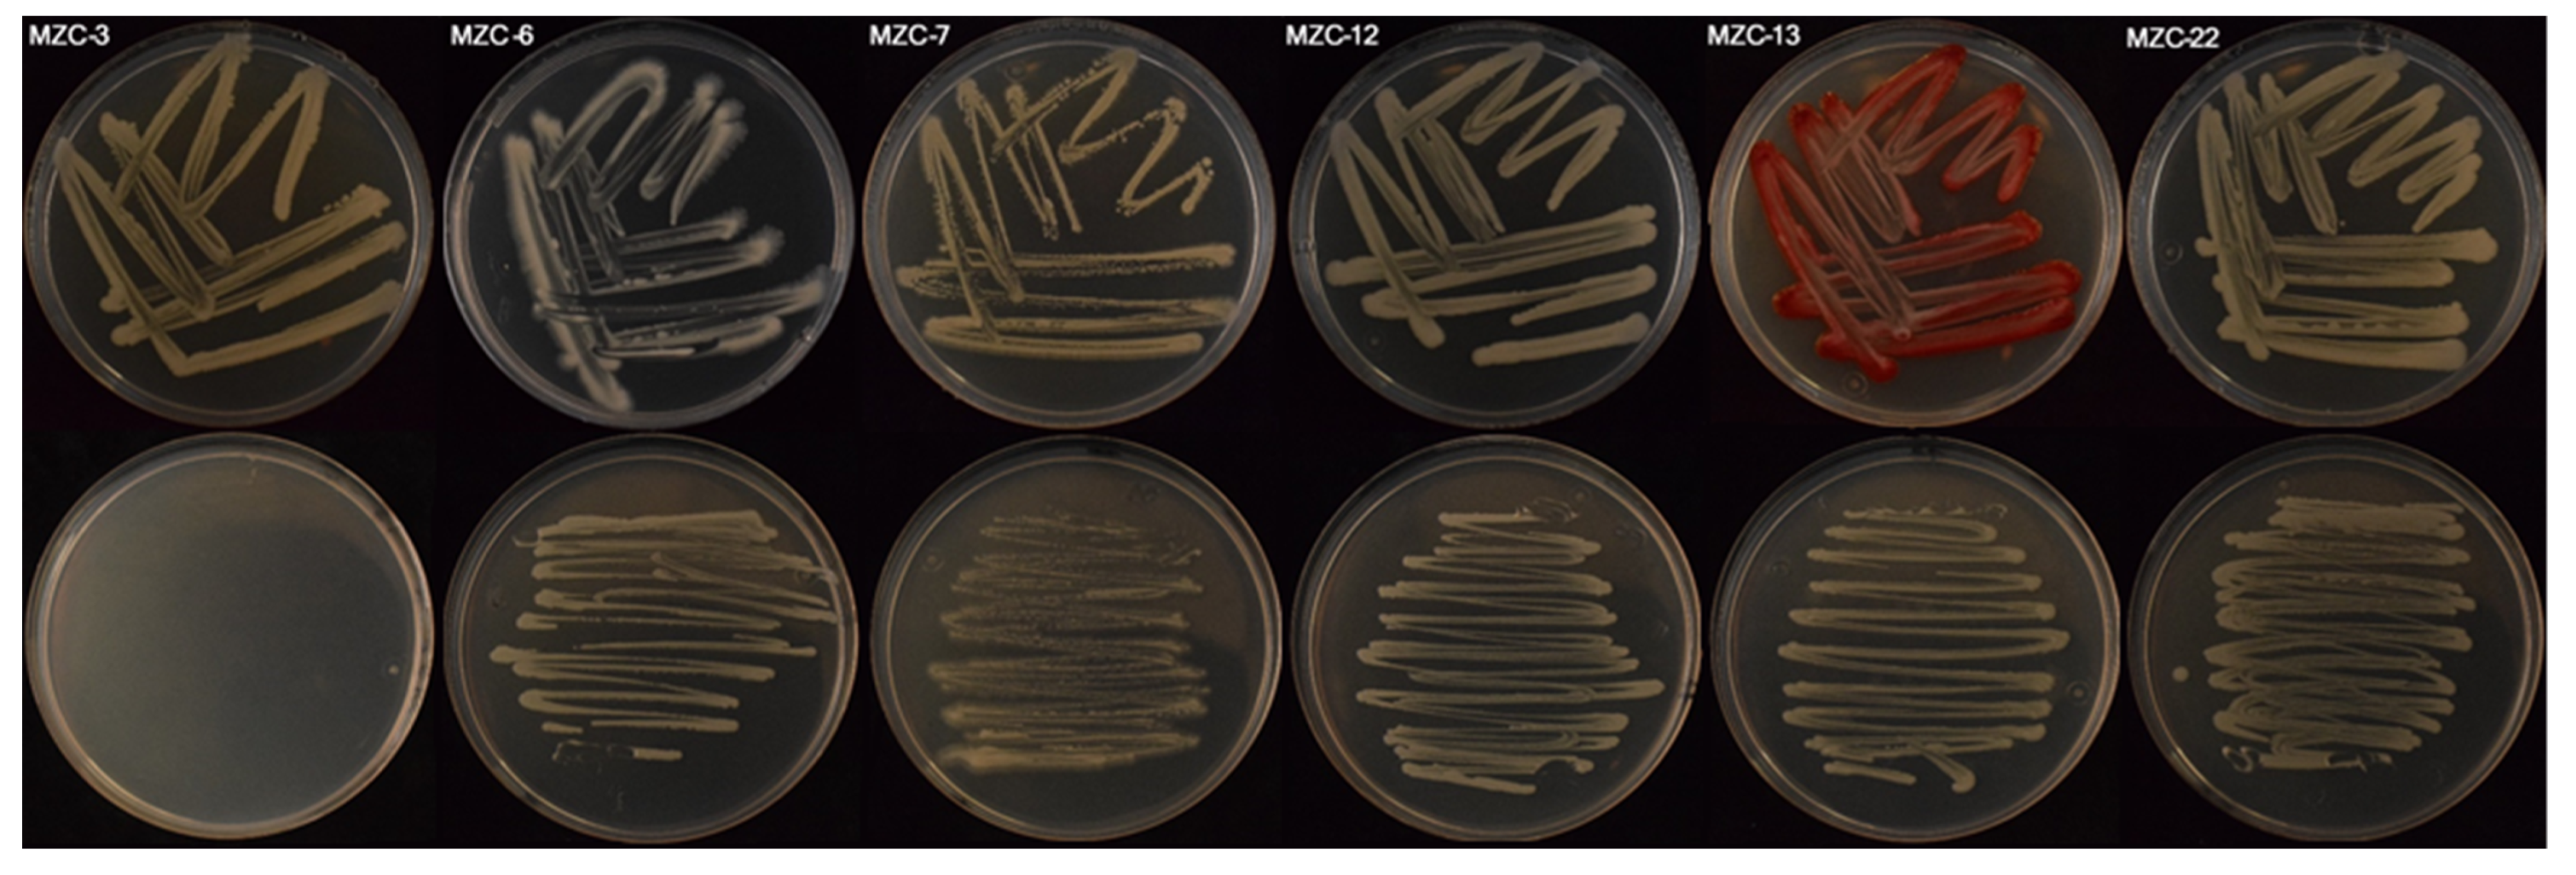
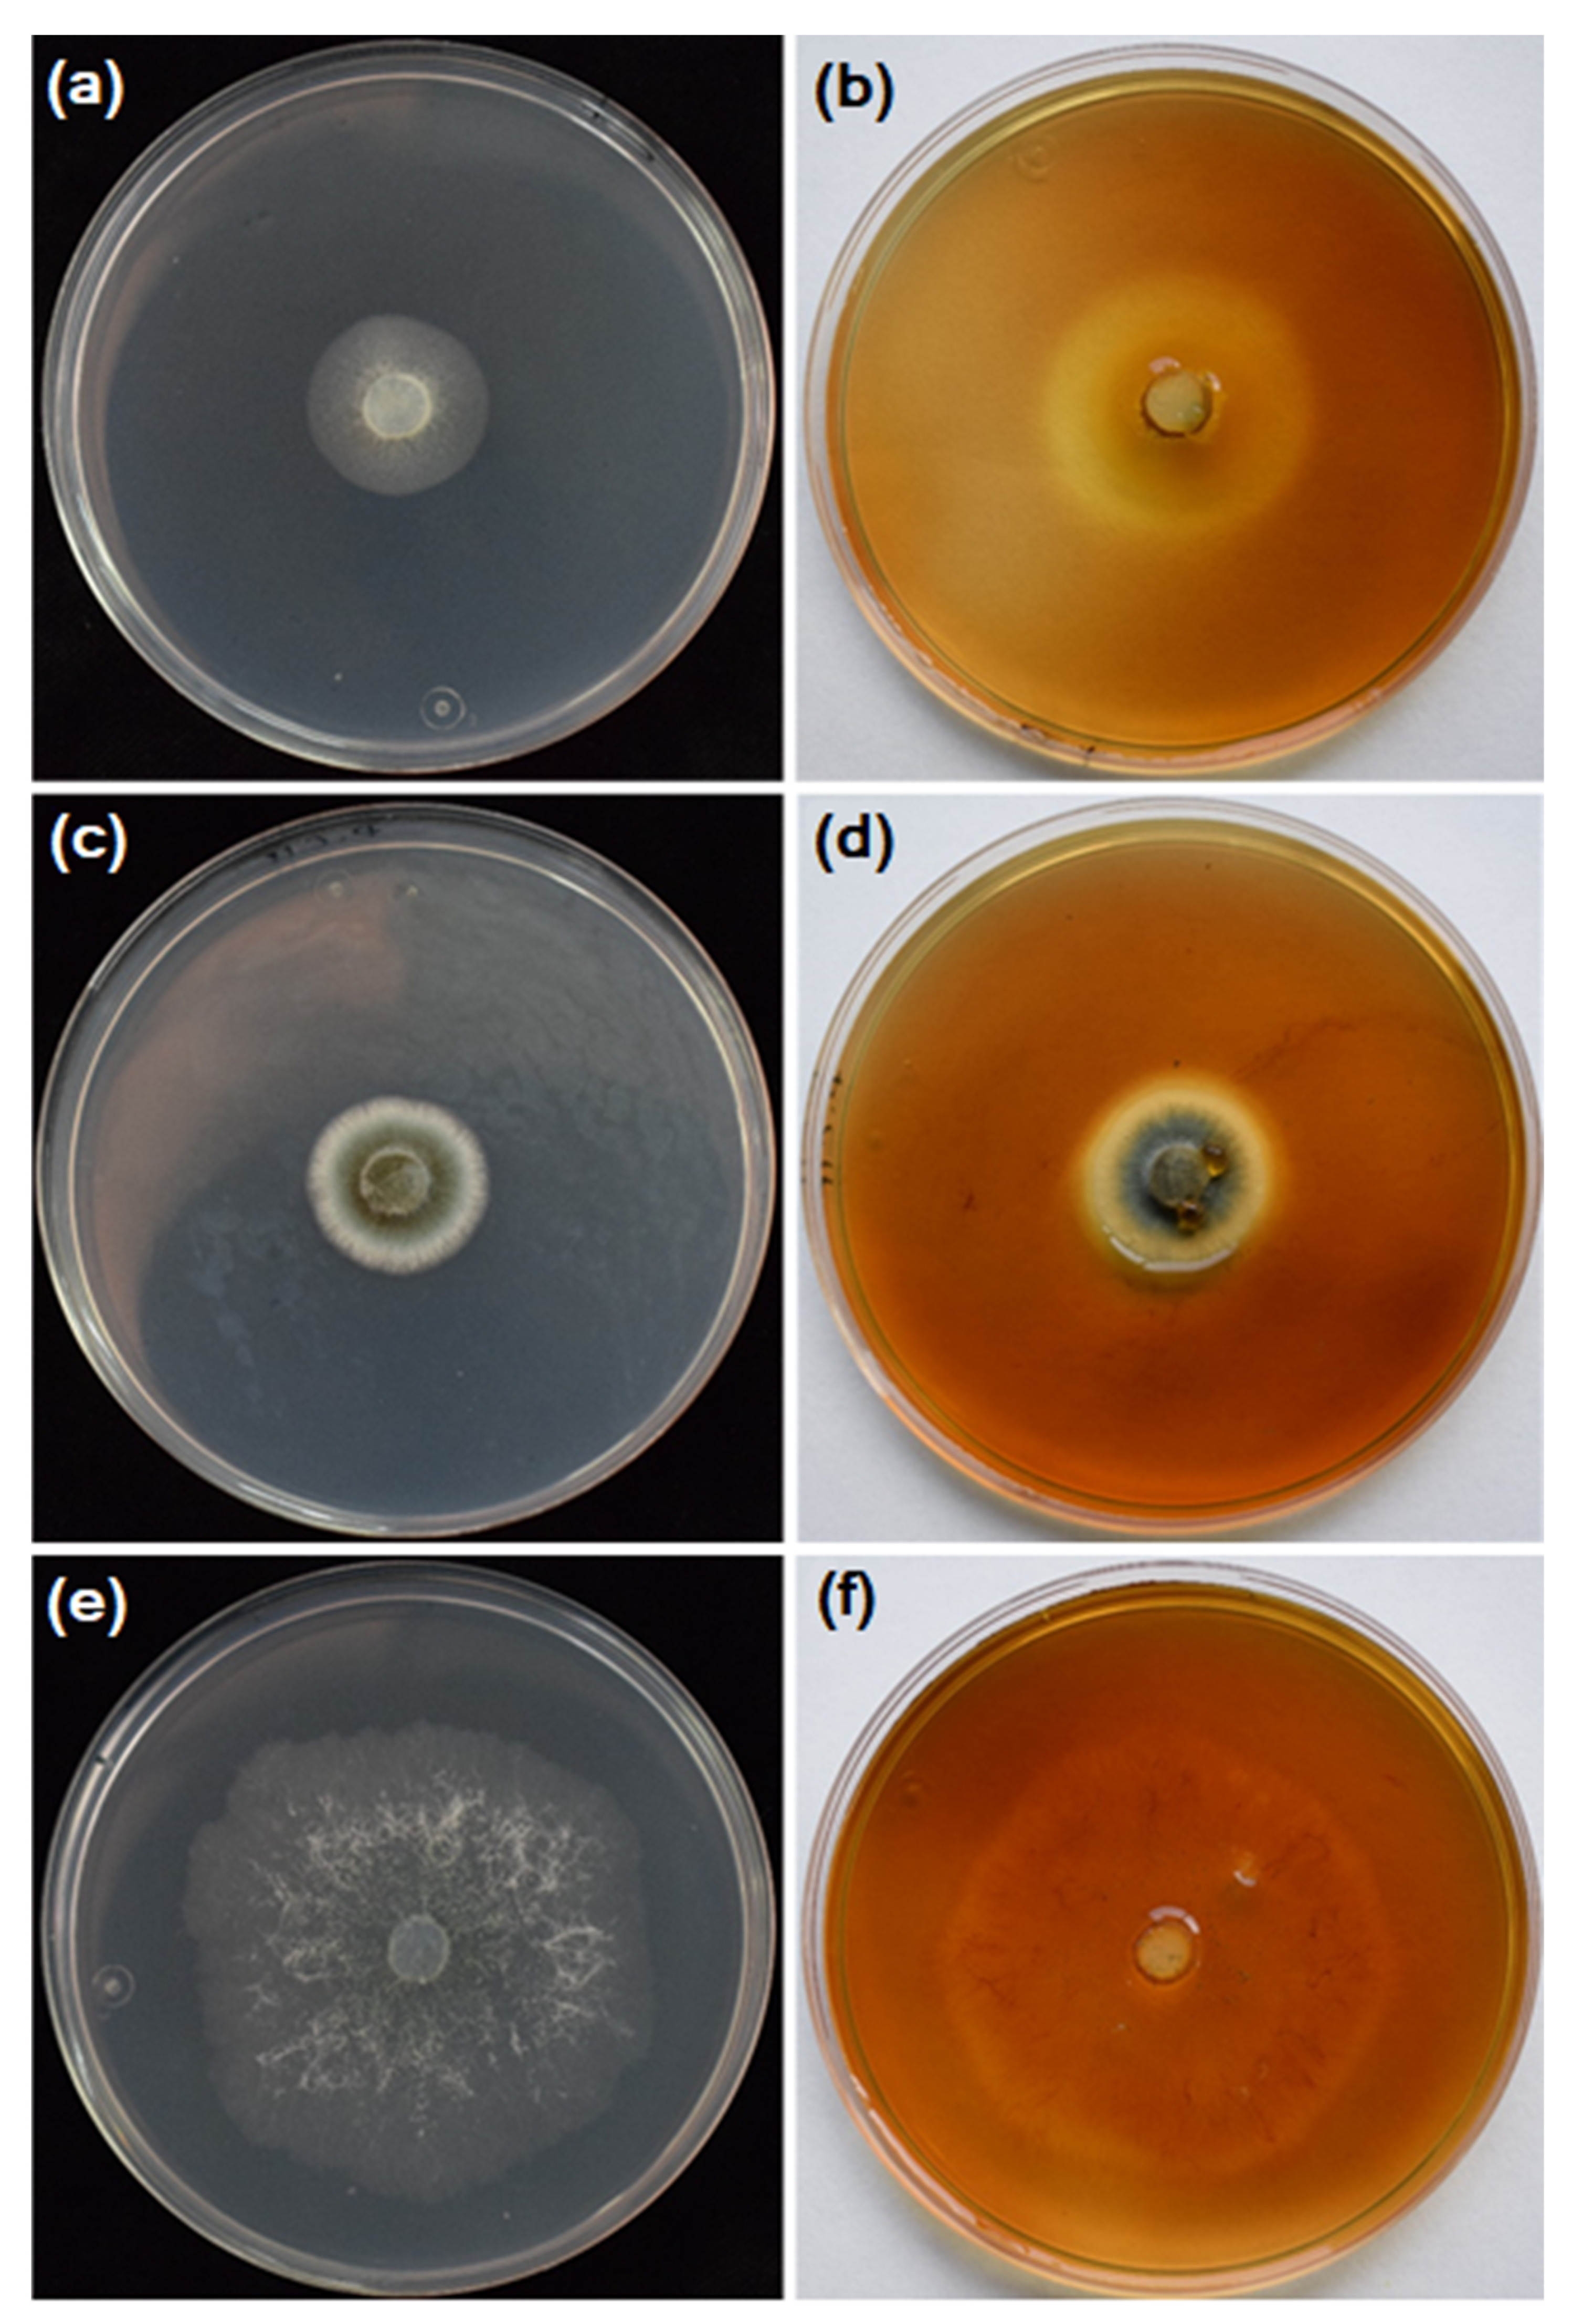

Diversity of Cellulolytic Microorganisms Associated with the Subterranean Termite Reticulitermes grassei
Abstract
1. Introduction
2. Materials and Methods
2.1. Field Sampling, Insect Collection, and Microorganism Isolation
2.1.1. Field Sampling
2.1.2. Microorganism Isolation
2.2. Microorganism Dispersion by the Termites under Controlled Conditions
2.3. Microorganism Isolates
2.4. Molecular Characterization
2.4.1. DNA Extraction
2.4.2. PCR Analysis
2.4.3. Blast Search
2.5. Phenotypic Characterization of Fungal Isolates
2.5.1. Fungal Colonies and Conidia Morphology
2.5.2. Effect of Temperature on Mycelial Growth
2.6. Phenotyphic and Biochemical Characterization of Bacterial Isolates
2.7. Evaluation of Cellulolytic Activity
3. Results
3.1. Field Sampling, Insect Collection, and Microorganism Isolation
3.2. Microorganism Dispersion by the Termites under Controlled Conditions
3.3. Molecular Characterization
3.4. Phenotypic Characterization of Fungal Isolates
3.4.1. Fungal Colonies and Conidia Morphology
3.4.2. Effect of Temperature on Mycelial Growth
3.5. Phenotyphic and Biochemical Characterization of Bacterial Isolates
3.6. Evaluation of Cellulolytic Activity
4. Discussion
Author Contributions
Funding
Institutional Review Board Statement
Informed Consent Statement
Data Availability Statement
Conflicts of Interest
References
- Romsaiyud, A.; Songkasiri, W.; Nopharatana, A.; Chaiprasert, P. Combination effect of pH and acetate on enzymatic cellulose hydrolysis. J. Environ. Sci. 2009, 21, 965–970. [Google Scholar] [CrossRef]
- Coughlan, M. Cellulose Degradation by Fungi; Elsevier Applied Science: London, UK, 1990. [Google Scholar]
- Dashtban, M.; Maki, M.; Leung, K.T.; Mao, C.; Qin, W. Cellulase activities in biomass conversion: Measurement methods and comparison. Crit. Rev. Biotechnol. 2010, 30, 302–309. [Google Scholar] [CrossRef]
- McDonald, J.E.; Rooks, D.J.; McCarthy, A.J. Methods for the isolation of cellulose-degrading microorganisms. Methods Enzymol. 2012, 510, 349–374. [Google Scholar]
- Esa, F.; Tasirin, S.M.; Rahman, N.A. Overview of bacterial cellulose production and application. Agric. Agric. Sci. Procedia 2014, 2, 113–119. [Google Scholar] [CrossRef]
- Kudo, T. Termite-microbe symbiotic system and its efficient degradation of lignocellulose. Biosci. Biotechnol. Biochem. 2009, 73, 2561–2567. [Google Scholar] [CrossRef]
- López-Casado, G.; Urbanowicz, B.R.; Damasceno, C.M.B.; Rose, J.K.C. Plant glycosyl hydrolases and biofuels: A natural marriage. Curr. Opin. Plant Biol. 2008, 11, 329–337. [Google Scholar] [CrossRef]
- Chaudhary, K.; Tauro, P. Selective induction of β-glucosidase in Trichoderma reesei by xylan. Eur. J. Appl. Microbiol. Biotechnol. 1982, 15, 185–187. [Google Scholar] [CrossRef]
- Mingardon, F.; Bagert, J.D.; Maisonnier, C.; Trudeau, D.L.; Arnold, F.H. Comparison of family 9 cellulases from mesophilic and thermophilic bacteria. Appl. Environ. Microbiol. 2011, 77, 1436–1442. [Google Scholar] [CrossRef]
- Zhang, Y.H.P.; Himmel, M.E.; Mielenz, J.R. Outlook for cellulose improvement: Screening and selection strategies. Biotechnol. Adv. 2006, 24, 452–481. [Google Scholar] [CrossRef]
- Ohkuma, M. Termite symbiotic systems: Efficient bio-recycling of lignocellulose. Appl. Microbiol. Biotechnol. 2003, 61, 1–9. [Google Scholar] [CrossRef]
- Jouquet, P.; Traoré, S.; Choosai, C.; Hartmann, C.; Bignell, D. Influence of termites on ecosystem functioning. Ecosystem services provided by termites. Eur. J. Soil Biol. 2011, 47, 215–222. [Google Scholar] [CrossRef]
- Watanabe, H.; Noda, H.; Tokuda, G.; Lo, N. A cellulase gene of termite origin. Nature 1998, 394, 330–331. [Google Scholar] [CrossRef]
- Grace, J.K.; Abdallay, A.; Farr, K.R. Eastern subterranean termite (Isoptera: Rhinotermitidae) foraging territories and populations in Toronto. Can. Entomol. 1989, 121, 551–556. [Google Scholar] [CrossRef]
- Konig, H. Bacillus species in the intestine of termites and other soil invertebrates. J. Appl. Microbiol. 2006, 101, 620–627. [Google Scholar] [CrossRef]
- Brune, A.; Dietrich, C. The Gut Microbiota of Termites: Digesting the Diversity in the Light of Ecology and Evolution. Ann. Rev. Microbiol. 2015, 69, 145–166. [Google Scholar] [CrossRef]
- Zoberi, M.H.; Grace, J.K. Fungi associated with subterranean termite Reticulitermes flavipes in Ontario. Mycologia 1990, 82, 284–289. [Google Scholar] [CrossRef]
- Wójcik, A.; Andres, B. Mildew fungi found in termites (Reticulitermes lucifugus) and their nests. J. Entomol. Acarol. Res. 2015, 47, 16–19. [Google Scholar]
- Ramin, M.; Alimon, A.; Abdullah, N. Identification of cellulolytic bacteria isolated from the termite Coptotermes curvignathus (Holmgren). J. Rapid Meth. Automation Microbiol. 2009, 17, 103–116. [Google Scholar] [CrossRef]
- Vetrovský, T.; Soukup, P.; Stiblik, P.; Votýpková, K.; Chakraborty, A.; Larrañaga, I.O.; Sillam-Dussès, D.; Lo, N.; Bourguignon, T.; Baldrian, P.; et al. Termites host specific fungal communities that differ from those in their ambient environments. Fungal Ecol. 2020, 48, 100991. [Google Scholar] [CrossRef]
- Ulyshen, M.D. Wood decomposition as influenced by invertebrates. Biol. Rev. Camb. Philos. Soc. 2016, 91, 70–85. [Google Scholar] [CrossRef]
- Gallardo, P.; Cárdenas, A.M.; Gaju, M. Ocurrence of Reticulitermes grassei (Isoptera: Rhinotermitidae) on cork oaks in the southern Iberian Peninsula: Identification, description and incidence of the damage. Sociobiology 2010, 56, 675–687. [Google Scholar]
- Chouvenc, T.; Bardunias, P.; Li, H.-F.; Elliot, M.L.; Su, N.Y. Planar arenas for use in laboratory bioassay studies of subterranean termites (Rhinotermitidae). Fla. Entomol. 2011, 94, 817–826. [Google Scholar] [CrossRef]
- Su, N.Y.; La Fage, J.P. Differences in survival and feeding activity among colonies of the Formosan subterranean termite (Isoptera: Rhinotermitidae). Zeitschrift für Angew. Entomol. 1984, 97, 134–138. [Google Scholar] [CrossRef]
- Grace, J.K.; Yamamoto, R. Natural resistance of Alaska-cedar, redwood, and teak to Formosan subterranean termites. For. Prod. J. 1994, 44, 41–45. [Google Scholar]
- Morales-Ramos, J.A.; Rojas, M.G. Nutritional ecology of the formosan subterranean termite (Isoptera: Rhinotermitidae): Feeding response to commercial wood species. J. Econ. Entomol. 2001, 94, 516–523. [Google Scholar] [CrossRef]
- EN 118. Wood Preservatives: Determination of Preventive Action against Reticulitermes species (European Termites) (Laboratory Method); European Committee for Standardization; BSI Standards Publication, CEN-CENELEC: Brussels, Belgium, 2013. [Google Scholar]
- Kačík, F.; Veľková, V.; Šmíra, P.; Nasswettrová, A.; Kačíková, D.; Reinprecht, L. Release of terpenes from fir woods during its long-term use and in thermal treatment. Molecules 2012, 17, 9990. [Google Scholar] [CrossRef]
- Gallardo, P.; Cárdenas, A.M.; Murillo, R. Suitability of substrate for laboratory studies with the subterranean termite Reticulitermes grassei Clément (Isoptera: Rhinotermitidae). Sociobiology 2016, 63, 855–857. [Google Scholar] [CrossRef]
- White, T.J.; Bruns, T.; Lee, S.; Taylor, J. Amplification and direct sequencing of fungi ribosomal RNA genes for phylogenetics. In PCR Protocols. A Guide to Methods and Applications; Innis, M.A., Gelfand, D.H., Sninsky, J.J., White, T.J., Eds.; Elsevier Academic Press: San Diego, CA, USA, 1990; pp. 315–322. [Google Scholar]
- Glass, N.L.; Donaldson, G. Development of primer sets designed for use with PCR to amplify conserved genes from filamentous ascomycetes. Appl. Environ. Microbiol. 1995, 61, 1323–1330. [Google Scholar] [CrossRef]
- Cubeta, M.A.; Echandi, E.; Abernathy, T.; Vilgalys, R. Characterization of anastomosis groups of binucleate Rhizoctonia species using restriction analysis of an amplified ribosomal RNA gene. Phytopathology 1991, 81, 1395–1400. [Google Scholar] [CrossRef]
- Vilgalys, R.; Hester, M. Rapid genetic identification and mapping of enzymatically amplified ribosomal DNA from several Cryptococcus species. J. Bacteriol. 1990, 172, 4238–4246. [Google Scholar] [CrossRef]
- Lane, D.J. 16S/23S rRNA sequencing. In Nucleioc Acids Techniques in Bacterial Systematics; Stackebrandt, E., Goodfellow, M., Eds.; John Whileyand Sons: Chichester, UK, 1991; pp. 115–147. [Google Scholar]
- Barnett, H.L.; Hunter, B.B. Illustrated Genera of Imperfect Fungi, 4th ed.; APS Press: Saint Paul, MN, USA, 1989. [Google Scholar]
- Rayner, R.W. A mycological colour chart. Mycologia 1972, 64, 230–233. [Google Scholar]
- Hau, B.; Kranz, J. Mathematics and statistics for analyses in epidemiology. In Epidemics of Plant Diseases; Kranz, J., Ed.; Springer-Verlag: Berlin, Germany, 1990; pp. 15–21. [Google Scholar]
- López-Moral, A.; Raya-Ortega, M.C.; Agustí-Brisach, C.; Roca, L.; Lovera, M.; Luque, F.; Arquero, O.; Trapero, A. Morphological, pathogenic, and molecular characterization of Colletotrichum acutatum isolates causing almond anthracnose in Spain. Plant Dis. 2017, 101, 2034–2045. [Google Scholar] [CrossRef] [PubMed]
- Steel, R.G.D.; Torrie, J.H. Bioestadística, 2nd ed.; McGraw-Hill: Bogotá, Colombia, 1985. [Google Scholar]
- Anonymous. Analytical Software, Statistix10; User’s Manual; Anonimous: Tallahassee, FL, USA, 2013. [Google Scholar]
- Coico, R. Gram Staining. Curr. Protoc. Microbiol. 2005, 1, Appendix 3C. [Google Scholar]
- Hankin, L.; Anagtostakis, S. Media containing carboxymethylcellulose to detect CX cellulase activity of microorganisms. J. Gen. Microbiol 1977, 98, 109–115. [Google Scholar] [CrossRef] [PubMed]
- Priyanka, P.; Yuvraj, C.; Farha, S.; Aranganathan, V. Isolation of cellulose degrading fungi from soil and optimization for cellulase production using carboxy methyl cellulose. Int. J. Live sci. Pharma Res. 2017, 7, 57–60. [Google Scholar]
- Pang, J.; Liu, Z.Y.; Hao, M.; Zhang, Y.F.; Qi, Q.S. An isolated cellulolytic Escherichia coli from bovine rumen produces ethanol and hydrogen from corn straw. Biotechonol. Biofuel 2017, 10, 165–174. [Google Scholar] [CrossRef]
- Coronado-Ruiz, C.; Avendaño, R.; Escudero-Leyva, E.; Conejo-Barboza, G.; Chaverri, P.; Chavarría, M. Two new cellulolytic fungal species isolated from a 19th century art collection. Sci. Rep. 2018, 8, 7492. [Google Scholar] [CrossRef]
- Yeoh, H.H.; Khew, E.; Lim, G. A simple method for screening cellulolytic fungi. Mycologia 1985, 77, 161–162. [Google Scholar] [CrossRef]
- Kasana, R.C.; Salwan, R.; Dhar, H.; Dutt, S.; Gulati, A. A rapid and easy method for the detection of microbial cellulases on agar plates using Gram’s Iodine. Curr. Microbiol. 2008, 57, 503–507. [Google Scholar] [CrossRef]
- Johnsen, H.R.; Krause, K. Cellulase activity screening using pure carboxymethylcellulose: Application to soluble cellulolytic samples and to plant tissue prints. Int. J. Mol. Sci. 2014, 15, 830. [Google Scholar] [CrossRef]
- Florencio, C.; Couri, S.; Farinas, C.S. Correlation between agar plate screening and solid-state fermentation for the prediction of cellulase production by Trichoderma strains. Enzyme Res. 2012, 2012, 793708. [Google Scholar] [CrossRef]
- Andreyeva, I.N.; Ogorodnikova, T.I. Pigmentation of Serratia marcescens and spectral properties of prodigiosin. Microbiology 2015, 84, 28–33. [Google Scholar] [CrossRef]
- Gupta, P.; Samant, K.; Sahu, A. Isolation of cellulose-degrading bacteria and determination of their cellulolytic potential. Int. J. Microbiol. 2012, 6, 578925. [Google Scholar] [CrossRef]
- Pourramezan, Z.; Ghezelbash, G.R.; Romani, B.; Ziaei, S.; Hedayatkhah, A. Screening and identification of newly isolated cellulose-degrading bacteria from the gut of xylophagous termite Microcerotermes diversus (Silvestri). Microbiology 2012, 81, 736–742. [Google Scholar] [CrossRef]
- Butera, G.; Ferraro, C.; Alonzo, G.; Colazza, S.; Quatrini, P. The gut microbiota of the wood-feeding termite Reticulitermes lucifugus (Isoptera: Rhinotermitidae). Ann. Microbiol. 2016, 66, 253–260. [Google Scholar] [CrossRef]
- Ali, H.R.K.; Hemeda, N.F.; Abdelaliem, Y.F. Symbiotic cellulolytic bacteria from the gut of the subterranean termite Psammotermes hypostoma Desneux and their role in cellulose digestion. AMB Express 2019, 9, 111–119. [Google Scholar] [CrossRef]
- Guswenrivo, I.; Nagao, H.; Lee, C.Y. The diversity of soil fungus in and around termite mounds of Globitermes sulphureus (Haviland) (Blattodea: Termitidae) and response of subterranean termite to fungi. In Sustainable Future for Human Security; McLellan, B., Ed.; Springer: Singapore, 2018; pp. 37–52. [Google Scholar]
- De Mello, A.P.; Barbosa-Silva, A.M.; Bezerra-Gusmao, M.A. Fungi associated with nests of Nasutitermes corniger (Motschulsky) (Isoptera: Nasutitermitinae) in a semiarid region of Brazil. Entomotropica 2016, 31, 302–310. [Google Scholar]
- Kirker, G.T.; Wagner, T.L.; Diehl, S.V. Relationship between wood-inhabiting fungi and Reticulitermes spp. in four forest habitats of northeastern Mississippi. Int. Biodeterior. Biodegradation 2012, 72, 18–25. [Google Scholar] [CrossRef]
- Martin, J.S.; Bulmer, M.S. A lab-based study of temperate forest termite impacts on two common wood-rot fungi. Environ. Entomol. 2018, 20, 1–6. [Google Scholar] [CrossRef]
- Voloshchuk, N.; Knop, M.; Colby, T.; Kombrink, E.; Hennig, L.; Hofmann, D.; Sicker, D.; Gryganski, A.; Schulz, M. How Doratomyces stemonitis copes with benzoxazolin-2(3H)-one (BOA), its derivates and detoxification products. Chemoecology 2007, 17, 1–12. [Google Scholar] [CrossRef]
- Waller, D.A.; La Fage, J.P. Nutritional ecology of termites. In Nutritional Ecology of Insects, Mites, and Spiders; Slansky, F., Rodriguez, J.G., Eds.; Wiley: New York, NY, USA, 1987; pp. 487–532. [Google Scholar]
- Viana-Junior, A.B.; Côrtes, M.O.; Cornelissen, T.G.; Neves, F.S. Interactions between wood-inhabiting fungi and termites: A meta-analytical review. Arthropod Plant Interac. 2017, 12, 229–235. [Google Scholar] [CrossRef]
- Xiong, H.; Cai, J.; Chen, X.; Liang, S.; Wen, X.; Wang, C. The Effects of Trichoderma Fungi on the tunneling, aggregation, and colony-initiation preferences of black-winged subterranean termites, Odontotermes formosanus (Blattodea: Termitidae). Forests 2019, 10, 1020. [Google Scholar] [CrossRef]
- Jayasimha, P.; Henderson, G. Effect of Aspergillus flavus and Trichoderma harzianum on survival of Coptotermes formosanus (Isoptera: Rhinotermitidae). Sociobiology 2007, 49, 135–141. [Google Scholar]
- Weindling, R. Studies on a lethal principle effective in the parasite action of Trichoderma lignorom, Rhizoctonia solani and other soil fungi. Phytopathology 1934, 24, 1153–1179. [Google Scholar]
- Benítez, T.; Rincón, A.M.; Limón, M.C.; Codón, A.C. Biocontrol mechanisms of Trichoderma strains. Int. Microbiol. 2004, 7, 249–260. [Google Scholar] [PubMed]
- Wu, Q.; Sun, R.; Ni, M.; Yu, J.; Li, Y.; Yu, C.; Dou, K.; Ren, J.; Chen, J. Identification of a novel fungus, Trichoderma asperellum GDFS1009, and comprehensive evaluation of its biocontrol efficacy. PLoS ONE 2017, 12, e0179957. [Google Scholar] [CrossRef] [PubMed]
- Blaszczyk, L.; Strakowska, J.; Chelkowski, J.; Gąbka-Buszek, A.; Kaczmarek, J. Trichoderma species occurring on wood with decay symptoms in mountain forests in central Europe: Genetic and enzymatic characterization. J. Appl. Genet. 2016, 56, 397–407. [Google Scholar] [CrossRef]
- Wanmolee, W.; Sornlake, W.; Rattanaphan, N.; Suwannarangsee, S.; Laosiripojana, N.; Champreda, V. Biochemical characterization and synergism of cellulolytic enzyme system from Chaetomium globosum on rice straw saccharification. BMC Biotechnol. 2016, 16, 82–94. [Google Scholar] [CrossRef]
- Di Pietro, A.; Gut-Rella, M.; Pachlatko, J.P.; Schwinn, F.J. Role of antibiotics produced by Chaetomium globosum in biocontrol of Pythium ultimum, a causal agent of damping-off. Phytopathology 1992, 82, 131–135. [Google Scholar] [CrossRef]
- Yan, W.; Cao, L.-L.; Zhang, Y.-Y.; Zhao, R.; Zhao, S.-S.; Khan, B.; Ye, Y.-H. New metabolites from endophytic fungus Chaetomium globosum CDW7. Molecules 2018, 23, 2873. [Google Scholar] [CrossRef]
- Longoni, P.; Rodolfi, M.; Pantaleoni, L.; Doria, E.; Concia, L.; Picco, A.M.; Cella, R. Functional analysis of the degradation of cellulosic S by a Chaetomium globosum endophytic isolate. Appl. Environ. Microbiol. 2012, 78, 3693–3705. [Google Scholar] [CrossRef] [PubMed]
- Wang, Q.; Lin, H.; Shen, Q.; Fan, X.; Bai, N.; Zhao, Y. Characterization of cellulase secretion and Cre1-mediated carbon source repression in the potential lignocellulose-degrading strain Trichoderma asperellum T-1. PLoS ONE 2015, 10, e0119237. [Google Scholar] [CrossRef] [PubMed]
- Gilliam, M.; Vandenberg, J.D. Fungi. In Honey Bee Pests, Predators and Diseases, 2nd ed.; Morse, R.A., Nowogrodzki, R., Eds.; Cornell University Press: Ithaca, NY, USA, 1990; pp. 64–90. [Google Scholar]
- Scully, L.R.; Bidochka, M.J. Serial passage of the opportunistic pathogen Aspergillus flavus through an insect host yields decreased saprobic capacity. Can. J. Microbiol. 2005, 51, 185–189. [Google Scholar] [CrossRef] [PubMed]
- St. Leger, R.J.; Screen, S.E.; Shams-Pirzadeh, B. Lack of host specialization in Aspergillus flavus. Appl. Environ. Microbiol. 2000, 66, 320–324. [Google Scholar] [CrossRef]
- Klich, M.A. Aspergillus flavus: The major producer of aflatoxin. Mol. Plant Pathol. 2007, 8, 713–722. [Google Scholar] [CrossRef]
- Al-Abdalall, A.H.A. Production of aflatoxins by Aspergillus flavus and Aspergillus niger strains isolated from seeds of pulses. J. Food Agric. Environ. 2009, 7, 33–39. [Google Scholar]
- Wei, H.; Wang, W.; Yarbrough, J.M.; Baker, J.O.; Laurens, L.; Van Wychen, S.; Chen, X.; Taylor II, L.E.; Xu, Q.; Himmel, M.E.; et al. Genomic, proteomic, and biochemical analyses of oleaginous Mucor circinelloides: Evaluating its capability in utilizing cellulolytic substrates for lipid production. PLoS ONE 2013, 8, e71068. [Google Scholar] [CrossRef]
- Vellanki, S.; Navarro-Mendoza, M.I.; Garcia, A.E.; Murcia, L.; Perez-Arques, C.; Garre, V.; Nicolas, F.E.; Lee, S.C. Mucor circinelloides: Growth, maintenance, and genetic manipulation. Curr. Prot. Microbiol. 2018, 49, e53. [Google Scholar] [CrossRef]
- Huang, G.; Zhou, H.; Tang, Z.; Liu, H.; Cao, Y.; Qiao, D.; Cao, Y. Novel fungal lipids for the production of biodiesel resources by Mucor fragilis AFT7-4. Environ. Prog. Sustain. Energy 2016, 35, 1784–1792. [Google Scholar] [CrossRef]
- Bardhan, P.; Gohain, M.; Daimary, N.; Kishor, S.; Chattopadhyay, P.; Gupta, K.; Chaliha, C.; Kalita, E.; Deka, D.; Mandal, M. Microbial lipids from cellulolytic oleaginous fungus Penicillium citrinum PKB20 as a potential feedstock for biodiesel production. Ann. Microbiol. 2019, 69, 1135–1146. [Google Scholar] [CrossRef]
- Peterson, R.; Grinyer, J.; Nevalainen, H. Secretome of the coprophilous fungus Doratomyces stemonitis C8, isolated from koala feces. Appl. Environ. Microbiol. 2011, 77, 3793–3801. [Google Scholar] [CrossRef]
- Li, T.; Jiang, G.; Qu, H.; Wang, Y.; Xiong, Y.; Jian, Q.; Wu, Y.; Duan, X.; Zhu, X.; Hu, W.; et al. Comparative transcriptome analysis of Penicillium citrinum cultured with different carbon sources identifies genes involved in citrinin biosynthesis. Toxins 2017, 9, 69. [Google Scholar] [CrossRef] [PubMed]
- Cárdenas, A.M.; Gallardo, P.; Carbonero-Pacheco, J.R.; Trillo, M. Response of the subterranean termite Reticulitermes grassei Clément (Isoptera: Rhinotermitidae) to pH of substrate. Pedobiologia 2020, 78, 150608. [Google Scholar] [CrossRef]
- Enagbonma, B.J.; Babalola, O.O. Environmental sustainability: A review of termite mound soil material and its bacteria. Sustainability 2019, 11, 3847. [Google Scholar] [CrossRef]
- Grace, J.K.; Zoberi, M.H. Experimental evidence for transmission of Beauveria bassiana by Reticulitermes flavipes workers (Isoptera: Termitidae). Sociobiology 1992, 20, 23–28. [Google Scholar]
- Vieto, S.; Escudero-Leyva, E.; Avendaño, R.; Rechnitzer, N.; Barrantes-Madrigal, M.D.; Conejo-Barboza, G.; Herrera-Sancho, O.A.; Chaverri, P.; Chavarría, M. Biodeterioration and Cellulolytic Activity by Fungi Isolated from a Nineteenth-Century Painting at the National Theatre of Costa Rica. Fungal Biol. 2022, 126, 101–112. [Google Scholar] [CrossRef]
- Balla, A.; Silini, A.; Cherif-Silini, H.; Bouket, A.C.; Boudechicha, A.; Luptakova, L.; Alenezi, F.N.; Belbahri, L. Screening of Cellulolytic Bacteria from Various Ecosystems and Their Cellulases Production under Multi-Stress Conditions. Catalysts 2022, 12, 769. [Google Scholar] [CrossRef]
- Siddiquee, S.; Cheong, B.E.; Taslima, K.; Kausar, H.; Hasan, M.M. Separation and identification of volatile compounds from liquid cultures of Trichoderma harzianum by GC-MS using three different capillary columns. J. Chromatogr. Sci. 2012, 50, 358–367. [Google Scholar] [CrossRef] [PubMed]
- Obata, T.; Schoenefeld, S.; Krahnert, I.; Bergmann, S.; Scheffel, A.; Fernie, A.R. Gas-chromatography mass-spectrometry (GC-MS) based metabolite profiling reveals mannitol as a major storage carbohydrate in the coccolithophorid alga Emiliania huxleyi. Metabolites 2013, 3, 168. [Google Scholar] [CrossRef]
- Fogle, M.R.; Douglas, D.R.; Jumper, C.A.; Straus, D.C. Growth and mycotoxin production by Chaetomium globosum is favored in a neutral pH. International J. Mol. Sci. 2008, 9, 2357. [Google Scholar] [CrossRef]

| Gene 1 | Primer Pairs 2 | PCR Cycling Program (T-Time) | |||||
|---|---|---|---|---|---|---|---|
| Initial Denaturation | Amplification | Final Extension | |||||
| N° of Cycles | Denaturation | Annealing | Extension | ||||
| Fungal isolates | |||||||
| ITS | ITS4/ITS5 | 94 °C-3 min | 35 | 94 °C-30 s | 48 °C-30 s | 72 °C-45 s | 72 °C-10 min |
| TUB | Bt2a/Bt2b | 95 °C-3 min | 35 | 94 °C-15 s | 55 °C-15 s | 72 °C-1 min | 72 °C-7 min |
| LSU | LR0R/LR7 | 95 °C-3 min | 35 | 94 °C-15 s | 52 °C-15 s | 72 °C-1 min | 72 °C-7 min |
| Bacterial isolates | |||||||
| 16S rDNA | 27F/1492R | 94 °C-3 min | 30 | 94 °C-30 s | 55 °C-30 s | 72 °C-1 min | 72 °C-10 min |
| Species | Isolate 1 | Host (Plant) | Substrate/Conditions 2 | Genbank Accession 3 | Blast Accession 4 | Query Length | Gaps 5 | Identities 6 | Maximum Identity (%) |
|---|---|---|---|---|---|---|---|---|---|
| Internal Transcribed Spacer Region Gene (Fungal and Yeast Isolates) | |||||||||
| Aspergillus flavus | MZC-17 | Eucalyptus sp. | Wood/Field colonization | MN069570 | KX462773 | 589 | 1/584 | 58/3/584 | 99.8 |
| MZC-20 | Pinus pinea | Wood/Laboratory colonization | MN069573 | MH485381 | 586 | 0/581 | 581/581 | 100 | |
| Aspergillus niger | MZC-14 | Pinus pinea | Wood/Laboratory colonization | MN069568 | KM259827 | 626 | 1/599 | 599/599 | 100 |
| MZC-18 | Pinus pinea | Wood/Laboratory colonization | MN069571 | KM259827 | 623 | 0/623 | 623/623 | 100 | |
| Chaetomium globosum | MZC-2 | - | Filter paper/Laboratory colonization | MN069561 | KR014363 | 603 | 1/496 | 493/493 | 100 |
| MZC-9 | - | Filter paper/Laboratory colonization | MN069565 | KM268665 | 606 | 0/602 | 602/602 | 100 | |
| Doratomyces stemonitis | MZC-16 | Populus alba | Wood/Laboratory colonization | MN069569 | FR799473 | 588 | 2/588 | 583/588 | 99.1 |
| Mucor circinelloides | MZC-5 | - | Suspension from collected termites | MN069563 | HM641688 | 668 | 1/657 | 650/657 | 99.0 |
| MZC-23 | Populus alba | Wood/Laboratory colonization | MN069575 | JN561250 | 627 | 1/627 | 624/627 | 99.5 | |
| Mucor fragilis | MZC-1 | - | Suspension from collected termites | MN069560 | GU566275 | 664 | 1/662 | 659/662 | 99.5 |
| Penicillium chrysogenum | MZC-0 7 | - | - | MN069559 | KC009774 | 612 | 2/612 | 610/612 | 99.7 |
| Penicillium citrinum | MZC-21 | Pinus pinea | Wood/Laboratory colonization | MN069574 | KC344966 | 538 | 0/538 | 538/538 | 100 |
| Pichia guilliermondii | MZC-19 (Yeast) | Pinus pinea | Wood/Laboratory colonization | MN069572 | EF192233 | 631 | 4/621 | 616/621 | 99.1 |
| Trichoderma asperellum | MZC-8 | Eucalyptus sp. | Wood/Field colonization | MN069564 | KM268676 | 622 | 0/615 | 615/615 | 100 |
| MZC-10 | Eucalyptus sp. | Wood/Field colonization | MN069566 | EU280110 | 631 | 1/629 | 627/629 | 100 | |
| MZC-11 | Eucalyptus sp. | Wood/Field colonization | MN069567 | MH351209 | 591 | 0/589 | 588/589 | 99.8 | |
| MZC-24 | Eucalyptus sp. | Wood/Field colonization | MN069576 | EU280110 | 631 | 2/621 | 618/621 | 99.5 | |
| Trichoderma longibrachiatum | MZC-4 | Eucalyptus sp. | Wood/Field colonization | MN069562 | KJ174230 | 622 | 2/623 | 621/623 | 99.7 |
| 16S rDNA gene (Bacteria isolates) | |||||||||
| Burkholderia kirstenboschensis | MZC-3 | Populus alba | Wood/Laboratory colonization | NM069326 | HF674708 | 1367 | 2/1366 | 1353/1366 | 99.0 |
| Klebsiella aerogenes | MZC-13 | - | Suspension from collected termites | NM069330 | MH368390 | 1391 | 1/1391 | 1389/1391 | 99.9 |
| Lactococcus lactis subsp. cremoris | MZC-7 | - | Filter paper/Laboratory colonization | NM069328 | MK290341 | 1006 | 0/1006 | 1005/1006 | 99.9 |
| Serratia marcescens | MZC-6 | Pinus pinea | Wood/Laboratory colonization | NM069327 | CP018929 | 1397 | 0/1397 | 1397/1397 | 100 |
| MZC-12 | Pinus pinea | Wood/Laboratory colonization | NM069329 | MK157269 | 1012 | 1/1012 | 1008/1012 | 99.6 | |
| MZC-22 | Pinus pinea | Wood/Laboratory colonization | NM069331 | KR817904 | 1403 | 1/1403 | 1401/1403 | 99.9 | |
| Isolate 1 | Mycelium | ||||
|---|---|---|---|---|---|
| Obverse | Reverse | ||||
| Colour | Zonation | Margin | Colour | Zonation | |
| MZC-1 | Beige to light brown | No | Regular | Beige | No |
| MZC-2 | Light grey, white in the margins | No | Irregular | Dark grey, beige in the margin | No |
| MZC-4 | White, yellow pigmentation of culture medium | No | Regular | Yellow | No |
| MZC-5 | Beige to light brown | No | Regular | Beige | No |
| MZC-8 | White to dark green | No | Irregular | White to green-grey | No |
| MZC-9 | Light grey, white in the margins | No | Irregular | Dark grey, beige in the margin | No |
| MZC-10 | White to dark green | No | Irregular | White to green-grey | No |
| MZC-11 | White to dark green | No | Irregular | White to green-grey | No |
| MZC-14 | Black, white in the margins | No | Regular | White to light grey | No |
| MZC-16 | Olive green, white in the margins | No | Regular | Olive green, white in the margins | No |
| MZC-17 | Yellow-green, white in the margins | No | Regular | Beige to light brown | No |
| MZC-18 | Black, white in the margins | No | Regular | White to light grey | No |
| MZC-19 2 | Cream to yellow | - | - | Cream to yellow | - |
| MZC-20 | Yellow-green, white in the margins | No | Regular | Beige to light brown | No |
| MZC-21 | Green-grey, white in the margins | No | Regular | Yellow-white | No |
| MZC-23 | Beige to light brown | No | Regular | Beige | No |
| MZC-24 | White to dark green | No | Irregular | White to green-grey | No |
| Isolate | Conidia | |||
|---|---|---|---|---|
| Length × Width (µm) 1 | Length/Width 2 | Morphology | Colour | |
| MZC-1 | (3.9-) 6.1 (−8.8) × (2.6-) 4.2 (−6.7) | 1.51 ± 0.05 | Aseptate, abundant, small, rounded to ovoid | Hyaline |
| MZC-2 | (7.0-) 8.6 (−10.1) × (5.6-) 7.2 (−8.8) | 1.20 ± 0.02 | Aseptate, small, rounded to ovoid, thick wall, pointed ends | Hyaline |
| MZC-4 | (2.6-) 3.6 (−5.9) × (2.1-) 2.6 (−3.1) | 1.38 ± 0.06 | Aseptate, abundant, small, rounded to ovoid | Hyaline |
| MZC-5 | (4.3-) 5.4 (−6.5) × (4.0-) 4.9 (−5.6) | 1.13 ± 0.03 | Aseptate, abundant, small, rounded to ovoid | Hyaline |
| MZC-8 | (2.7-) 3.5 (−4.2) × (2.4-) 3.0 (−3.5) | 1.17 ± 0.04 | Aseptate, abundant, small, rounded to ovoid | Hyaline |
| MZC-9 | (7.1-) 8.7 (−10.3) × (4.5-) 6.7 (−8.2) | 1.32 ± 0.03 | Aseptate, small, rounded to ovoid, thick wall, pointed ends | Hyaline |
| MZC-10 | (2.7-) 3.3 (−4.2) × (2.2-) 2.6 (−3.7) | 1.17 ± 0.03 | Aseptate, abundant, small, rounded to ovoid | Hyaline |
| MZC-11 | (2.5-) 3.3 (−4.1) × (2.2-) 2.8 (−3.4) | 1.20 ± 0.03 | Aseptate, abundant, small, rounded to ovoid | Hyaline |
| MZC-14 | (2.8-) 3.9 (−4.9) × (3.1-) 3.8 (−5.4) | 1.05 ± 0.03 | Aseptate, abundant, small, rounded to ovoid | Hyaline, dark grey cell centre |
| MZC-16 | (4.3-) 5.3 (−6.7) × (2.7-) 3.7 (−4.6) | 1.47 ± 0.03 | Aseptate, small, ovoid, thick double wall, one rounded end, and other truncate | Hyaline |
| MZC-17 | (2.7-) 3.6 (−5.3) × (2.4-) 3.3 (−4.0) | 1.09 ± 0.02 | Aseptate, abundant, small, rounded to ovoid | Hyaline |
| MZC-18 | (3.3-) 3.7 (−4.2) × (3.3-) 3.7 (−4.3) | 1.00 ± 0.02 | Aseptate, abundant, small, rounded to ovoid | Hyaline, dark grey cell centre |
| MZC-19 3 | (2.4-) 4.0 (−8.2) × (1.3-) 2.0 (−2.5) | 2.11 ± 0.14 | Aseptate, abundant, small, rounded to ovoid | Hyaline |
| MZC-20 | (2.6-) 3.4 (−4.9) × (2.8-) 3.4 (−4.5) | 1.00 ± 0.02 | Aseptate, abundant, small, rounded to ovoid | Hyaline |
| MZC-21 | (1.8-) 2.2 (−2.5) × (1.9-) 2.2 (−2.5) | 1.00 ± 0.02 | Aseptate, abundant, small, rounded | Hyaline |
| MZC-23 | (3.6-) 4.6 (−6.7) × (2.5-) 3.9 (−5.7) | 1.22 ± 0.04 | Aseptate, abundant, small, rounded to ovoid | Hyaline |
| MZC-24 | (2.8-) 3.4 (−4.3) × (2.5-) 3.1 (−3.8) | 1.08 ± 0.03 | Aseptate, abundant, small, rounded | Hyaline |
| Isolate 1 | Analytics Beta Model 2 | Temperature (°C) 3,4 | MGR (mm Day−1) 4,5 | |||||
|---|---|---|---|---|---|---|---|---|
| R2 | a | b | Optimum | Minimum | Maximum | |||
| Aspergillus flavus | MZC-17 | 0.9939 | 2.27 | 0.80 | 31.6 ab | 5.0 | 41.0 | 5.6 gh |
| MZC-20 | 0.9989 | 1.79 | 1.18 | 30.9 bc | 13.5 | 42.5 | 5.3 h | |
| Aspergillus niger | MZC-14 | 0.9938 | 2.63 | 1.67 | 31.2 b | 10.0 | 42.5 | 6.9 g |
| MZC-18 | 0.9845 | 2.36 | 1.50 | 30.3 c | 12.0 | 42.0 | 6.6 gh | |
| Chaeotomium globosum | MZC-2 | 0.9865 | 1.74 | 0.99 | 24.4 f | 5.0 | 35.5 | 2.2 i |
| MZC-9 | 0.9668 | 1.16 | 0.90 | 22.2 g | 5.0 | 35.5 | 2.0 i | |
| Doratomyces stemonitis | MZC-16 | 0.9734 | 2.10 | 0.97 | 24.1 f | 6.0 | 32.5 | 2.0 i |
| Mucor circinelloides | MZC-5 | 0.9475 | 1.97 | 0.58 | 25.2 d | 3.5 | 35.5 | 10.4 e |
| MZC-23 | 0.9621 | 1.03 | 0.32 | 28.3 d | 5.0 | 35.5 | 11.0 e | |
| Mucor fragilis | MZC-1 | 0.9811 | 1.47 | 0.73 | 24.7 f | 4.0 | 35.0 | 8.6 f |
| Penicillium citrinum | MZC-21 | 0.9992 | 1.24 | 0.62 | 27.7 de | 12.0 | 35.5 | 1.8 i |
| Trichoderma asperellum | MZC-8 | 0.9970 | 2.39 | 0.91 | 27.8 de | 7.5 | 35.5 | 13.3 d |
| MZC-10 | 0.9920 | 3.38 | 1.18 | 27.6 de | 5.0 | 35.5 | 13.9 cd | |
| MZC-11 | 0.9915 | 2.60 | 0.92 | 27.5 e | 5.0 | 35.5 | 15.2 bc | |
| MZC-24 | 0.9966 | 3.58 | 1.29 | 27.1 e | 5.0 | 35.5 | 16.3 b | |
| Trichoderma longibrachiatum | MZC-4 | 0.9957 | 2.97 | 0.96 | 32.1 a | 6.0 | 40.5 | 33.6 a |
| Fungal Species | Isolate 1 | Radial Growth (mm day−1) 2 | Enzymatic Index 3 |
|---|---|---|---|
| Aspergillus flavus | MZC-17 | 6.6 ± 0.58 e | 1.08 ± 0.041 cd |
| MZC-20 | 4.5 ± 0.01 f | 1.11 ± 0.019 c | |
| Aspergillus niger | MZC-14 | 5.1 ± 0.25 f | 1.06 ± 0.006 cd |
| MZC-18 | 5.0 ± 0.12 f | 1.00 ± 0.001 e | |
| Chaetomium globosum | MZC-2 | 3.3 ± 0.17 g | 1.00 ± 0.001 e |
| MZC-9 | 3.6 ± 0.11 g | 1.00 ± 0.001 e | |
| Doratomyces stemonitis | MZC-16 | 2.3 ± 0.08 h | 1.05 ± 0.052 d |
| Mucor circinelloides | MZC-5 | 7.3 ± 0.87 de | 1.00 ± 0.001 e |
| MZC-23 | 9.0 ± 0.36 b | 1.00 ± 0.001 e | |
| Mucor fragilis | MZC-1 | 7.3 ± 0.22 de | 1.00 ± 0.001 e |
| Penicillium chrysogenum | MCZ-0 4 | 1.7 ± 0.02 h | 1.50 ± 0.011 a |
| Penicillium citrinum | MZC-21 | 1.6 ± 0.17 h | 1.34 ± 0.020 b |
| Trichoderma asperellum | MZC-8 | 7.5 ± 0.31 cd | 1.0 ± 0.001 e |
| MZC-10 | 8.3 ± 0.07 bc | 1.0 ± 0.001 e | |
| MZC-11 | 8.5 ± 0.22 b | 1.0 ± 0.001 e | |
| MZC-24 | 7.5 ± 0.15 cd | 1.0 ± 0.001 e | |
| Trichoderma longibrachiatum | MZC-4 | 10.9 ± 0.15 a | 1.09 ± 0.008 cd |
Disclaimer/Publisher’s Note: The statements, opinions and data contained in all publications are solely those of the individual author(s) and contributor(s) and not of MDPI and/or the editor(s). MDPI and/or the editor(s) disclaim responsibility for any injury to people or property resulting from any ideas, methods, instructions or products referred to in the content. |
© 2023 by the authors. Licensee MDPI, Basel, Switzerland. This article is an open access article distributed under the terms and conditions of the Creative Commons Attribution (CC BY) license (https://creativecommons.org/licenses/by/4.0/).
Share and Cite
Carbonero-Pacheco, J.; Aguilar, J.; Raya, M.C.; Trapero, A.; Gaju-Ricart, M.; Agustí-Brisach, C. Diversity of Cellulolytic Microorganisms Associated with the Subterranean Termite Reticulitermes grassei. J. Fungi 2023, 9, 294. https://doi.org/10.3390/jof9030294
Carbonero-Pacheco J, Aguilar J, Raya MC, Trapero A, Gaju-Ricart M, Agustí-Brisach C. Diversity of Cellulolytic Microorganisms Associated with the Subterranean Termite Reticulitermes grassei. Journal of Fungi. 2023; 9(3):294. https://doi.org/10.3390/jof9030294
Chicago/Turabian StyleCarbonero-Pacheco, Juan, José Aguilar, María Carmen Raya, Antonio Trapero, Miquel Gaju-Ricart, and Carlos Agustí-Brisach. 2023. "Diversity of Cellulolytic Microorganisms Associated with the Subterranean Termite Reticulitermes grassei" Journal of Fungi 9, no. 3: 294. https://doi.org/10.3390/jof9030294
APA StyleCarbonero-Pacheco, J., Aguilar, J., Raya, M. C., Trapero, A., Gaju-Ricart, M., & Agustí-Brisach, C. (2023). Diversity of Cellulolytic Microorganisms Associated with the Subterranean Termite Reticulitermes grassei. Journal of Fungi, 9(3), 294. https://doi.org/10.3390/jof9030294

